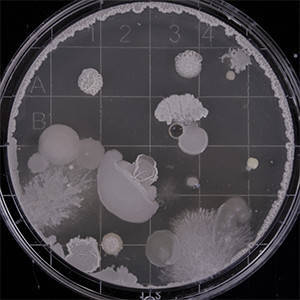

Herbal Supplements
Filter
Showing 1–24 of 38 results
Featured! - 25%




Paxherbal Mistleaves Tea: Herbal Tea for General Well-being (25 Teabags, 50g)
★★★★★
Original price was: €8.40.€6.30Current price is: €6.30.


Editor choice

![Paxherbal Diatea Herbal Tea: Natural Support for Healthy Blood Sugar, Cholesterol & Blood Pressure (25 Tea Bags) product image[paxyou.com]](https://www.paxyou.com/wp-content/uploads/2019/02/diatea[paxyou.com].jpg)


























